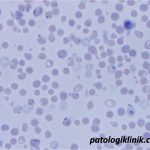
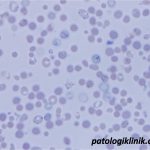
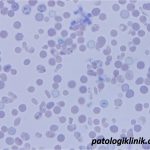

Gambaran Golf Ball Inclusion pada Thalassemia Alfa
Gambaran inklusi bola golf (golf ball inclusions) pada sel darah merah tampak setelah dilakukan pengecatan BCB dengan inkubasi. Gambarannya berupa titik-titik bulat berwarna biru kehijauan baik di dalam maupun di keliling luar sel dengan pola seperti bola golf. Badan inklusi ini bisa dibedakan dari retikulosit yang berwarna lebih gelap dengan titik atau filamen retikulosit yang jarang dan tidak merata.
Gambaran golf ball ini merupakan pemeriksaan diagnostik untuk thalassemia alfa yang dapat dilakukan tanpa pemeriksaan molekuler atau genetik.